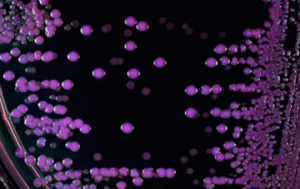

Колонії патогенної бактерії Bacillus cereus на кров’яному агарі. Колонии патогенной бактерии Bacillus cereus на кровяном агаре. Colonies of pathogenic bacteria Bacillus cereus on blood agar. Les colonies de bactéries pathogènes de Bacillus cereus sur gélose au sang. Las colonias de bacterias patógenas Bacillus cereus en agar sangre. Kolonien von pathogenen Bakterien, Bacillus cereus auf […]
